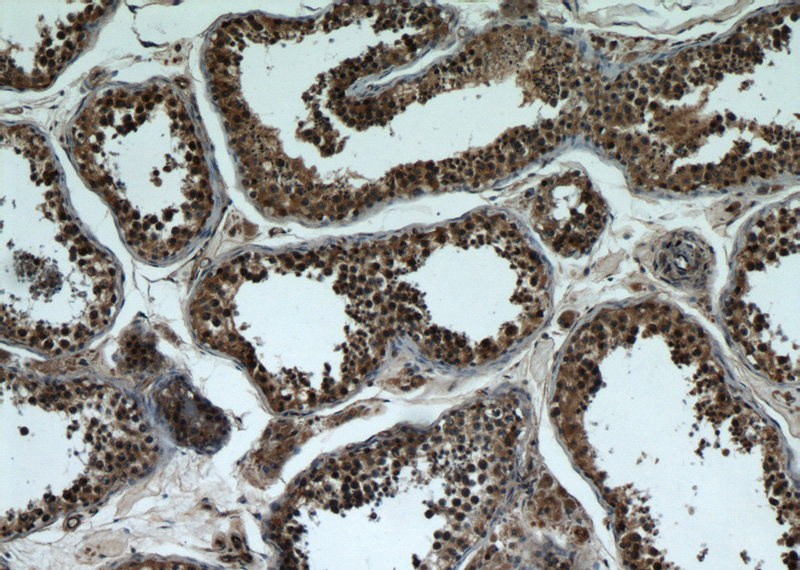
Immunohistochemical of paraffin-embedded human testis using Catalog No:108375(BBS7 antibody) at dilution of 1:50 (under 10x lens)

-
Product Name
BBS7 antibody
- Documents
-
Description
BBS7 Rabbit Polyclonal antibody. Positive IHC detected in human testis tissue, human brain tissue. Positive WB detected in human brain tissue. Positive IP detected in mouse testis tissue. Observed molecular weight by Western-blot: 75kd
-
Tested applications
ELISA, WB, IHC, IP
-
Species reactivity
Human, Mouse; other species not tested.
-
Alternative names
Bardet Biedl syndrome 7 antibody; BBS2 like protein 1 antibody; BBS2L1 antibody; BBS7 antibody; FLJ10715 antibody
-
Isotype
Rabbit IgG
-
Preparation
This antibody was obtained by immunization of BBS7 recombinant protein (Accession Number: NM_018190). Purification method: Antigen affinity purified.
-
Clonality
Polyclonal
-
Formulation
PBS with 0.02% sodium azide and 50% glycerol pH 7.3.
-
Storage instructions
Store at -20℃. DO NOT ALIQUOT
-
Applications
Recommended Dilution:
WB: 1:500-1:5000
IP: 1:200-1:2000
IHC: 1:20-1:200
-
Validations

human brain tissue were subjected to SDS PAGE followed by western blot with Catalog No:108375(BBS7 antibody) at dilution of 1:1500
Immunohistochemical of paraffin-embedded human testis using Catalog No:108375(BBS7 antibody) at dilution of 1:50 (under 10x lens)

Immunohistochemical of paraffin-embedded human testis using Catalog No:108375(BBS7 antibody) at dilution of 1:50 (under 40x lens)

IP Result of anti-BBS7 (IP:Catalog No:108375, 4ug; Detection:Catalog No:108375 1:500) with mouse testis tissue lysate 4000ug.
-
Background
BBS7, also named as BBS2L1, is a component of the BBSome complex which is required for ciliogenesis but is dispensable for centriolar satellite function. BBS7 is mediated in part by the Rab8 GDP/GTP exchange factor, which localizes to the basal body and contacts the BBSome.
-
References
- Seo S, Zhang Q, Bugge K. A novel protein LZTFL1 regulates ciliary trafficking of the BBSome and Smoothened. PLoS genetics. 7(11):e1002358. 2011.
- Chamling X, Seo S, Searby CC, Kim G, Slusarski DC, Sheffield VC. The centriolar satellite protein AZI1 interacts with BBS4 and regulates ciliary trafficking of the BBSome. PLoS genetics. 10(2):e1004083. 2014.
- Sinha S, Belcastro M, Datta P, Seo S, Sokolov M. Essential role of the chaperonin CCT in rod outer segment biogenesis. Investigative ophthalmology & visual science. 55(6):3775-85. 2014.
- Datta P, Allamargot C, Hudson JS. Accumulation of non-outer segment proteins in the outer segment underlies photoreceptor degeneration in Bardet-Biedl syndrome. Proceedings of the National Academy of Sciences of the United States of America. 112(32):E4400-9. 2015.
Related Products / Services
Please note: All products are "FOR RESEARCH USE ONLY AND ARE NOT INTENDED FOR DIAGNOSTIC OR THERAPEUTIC USE"
